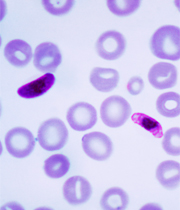
Imagen

Científicos de EE.UU. descubrieron químico vital para el parásito de la malaria
Supone el primer paso para experimentar con una nueva vacuna.
El componente es crucial para la subsistencia de Plasmodium falciparum.
Supone el primer paso para experimentar con una nueva vacuna.
El componente es crucial para la subsistencia de Plasmodium falciparum.



Científicos descubrieron uno de los elementos químicos cruciales que permiten al parásito de la malaria proliferar en la sangre humana, lo que abre una puerta hacia nuevos tratamientos contra la enfermedad, según un estudio publicado este miércoles la revista PlOS Biology.
El resultado de la investigación realizada por Joseph DeRisi y Ellen Yeh, bioquímicos de las universidades de California y Stanford, supone el primer paso para experimentar con una nueva vacuna al identificar el isopentenil pirofosfato, un componente indispensable del parásito Plasmodium falciparum para construir diversas moléculas cruciales para su subsistencia.
El resultado de la investigación realizada por Joseph DeRisi y Ellen Yeh, bioquímicos de las universidades de California y Stanford, supone el primer paso para experimentar con una nueva vacuna al identificar el isopentenil pirofosfato, un componente indispensable del parásito Plasmodium falciparum para construir diversas moléculas cruciales para su subsistencia.
Los científicos desarrollarán ahora una versión debilitada de este parásito en el laboratorio al que suministrarán el componente necesario para su supervivencia, a la vez que eliminarán su capacidad para producirlo por sí mismo. Posteriormente, inocularán esta vacunas a personas que viven en regiones donde abunda la malaria.
Si funciona, el parásito modificado no enfermaría a las personas, pero sí les permitiría desarrollar resistencia para cuando se enfrenten a la versión real del Plasmodium falciparum.
"Es como si hubiéramos diseñado una bomba de relojería dentro del parásito que está lista para explotar y cuando lo hace el parásito muere", explicó DeRisi, director del estudio.
Este nuevo hallazgo permite identificar exactamente uno de los elementos imprescindibles para la supervivencia del parásito en la sangre humana, lo que facilita el desarrollo de fármacos destinados específicamente a desactivar la enfermedad.